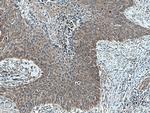
A4GALT Antibody in Immunohistochemistry (Paraffin) (IHC (P))

Search
Proteintech
A4GALT Polyclonal Antibody
{{$productOrderCtrl.translations['antibody.pdp.commerceCard.promotion.promotions']}}
{{$productOrderCtrl.translations['antibody.pdp.commerceCard.promotion.viewpromo']}}
{{$productOrderCtrl.translations['antibody.pdp.commerceCard.promotion.promocode']}}: {{promo.promoCode}} {{promo.promoTitle}} {{promo.promoDescription}}. {{$productOrderCtrl.translations['antibody.pdp.commerceCard.promotion.learnmore']}}
产品信息
12392-1-AP
种属反应
宿主/亚型
分类
类型
抗原
偶联物
形式
浓度
规格
纯化类型
保存液
内含物
保存条件
运输条件
产品详细信息
Immunogen sequence: HVVGEPKEK GQLYNLPAEI PCPTLTPPTP PSHGPTPGNI FFLETSDRTN PNFLFMCSVE SAARTHPESH VLVLMKGLPG GNASLPRHLG ISLLSCFPNV QMLPLDLREL FRDTPLADWY AAVQGRWEPY LLPVLSDASR IALMWKFGGI YLDTDFIVLK NLRNLTNVLG TQSRYVLNGA FLAFERRHEF MALCMRDFVD HYNGWIWGHQ GPQLLTRVFK KWCSIRSLAE SRACRGVTTL PPEAFYPIPW QDWKKYFEDI NPEELPRLLS ATYAVHVWNK KSQGTRFEAT SRALLAQLHA RYCPTTHEAM KMYL (41-353 aa encoded by BC017068)
靶标信息
The protein encoded by this gene catalyzes the transfer of galactose to lactosylceramide to form globotriaosylceramide, which has been identified as the P(k) antigen of the P blood group system. The encoded protein, which is a type II membrane protein found in the Golgi, is also required for the synthesis of the bacterial verotoxins receptor.
仅用于科研。不用于诊断过程。未经明确授权不得转售。
篇参考文献 (0)
生物信息学
蛋白别名: A4galt; alpha 1,4-galactosyltransferase (P blood group); alpha 14-galactosyltransferase; Alpha-1,4-galactosyltransferase; Alpha-1,4-N-acetylglucosaminyltransferase; Alpha4Gal-T1; cd77; CD77 synthase; GB3 synthase; Gb3/CD77 synthase; Globotriaosylceramide synthase; lac; Lactosylceramide 4-alpha-galactosyltransferase; P blood group (P one antigen); P one antigen (P blood group); P(k) antigen synthase; P1/Pk synthase; UDP-galactose:beta-D-galactosyl-beta1-R 4-alpha-D-galactosyltransferase; unnamed protein product
基因别名: A14GALT; A4GALT; A4GALT1; Gb3S; P(k); P1; P1PK; PK
UniProt ID: (Human) Q9NPC4, (Mouse) Q67BJ4
Entrez Gene ID: (Human) 53947, (Mouse) 239559